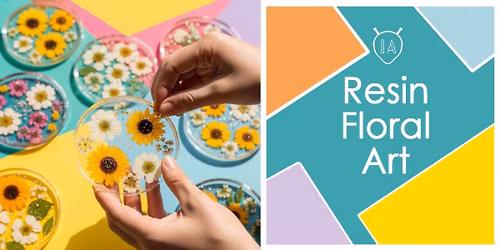
Resin FLORAL Art

MastiCore Improv Comedy Show
Schedule
Sat, 29 Nov, 2025 at 07:00 pm
UTC+05:30Location
Topcat Retired Comedy Club: Kolkata | Kolkata, WB
Watch Kolkata`s funniest comedians take the stage and turn your suggestions into hilarious scenes!
No script. Only laughter.
This is MastiCore Improv!
Where is it happening?
Topcat Retired Comedy Club: Kolkata, 36/F, Topsia Road, Topsia, Kolkata, West Bengal 700039, IndiaEvent Location & Nearby Stays:
INR 199